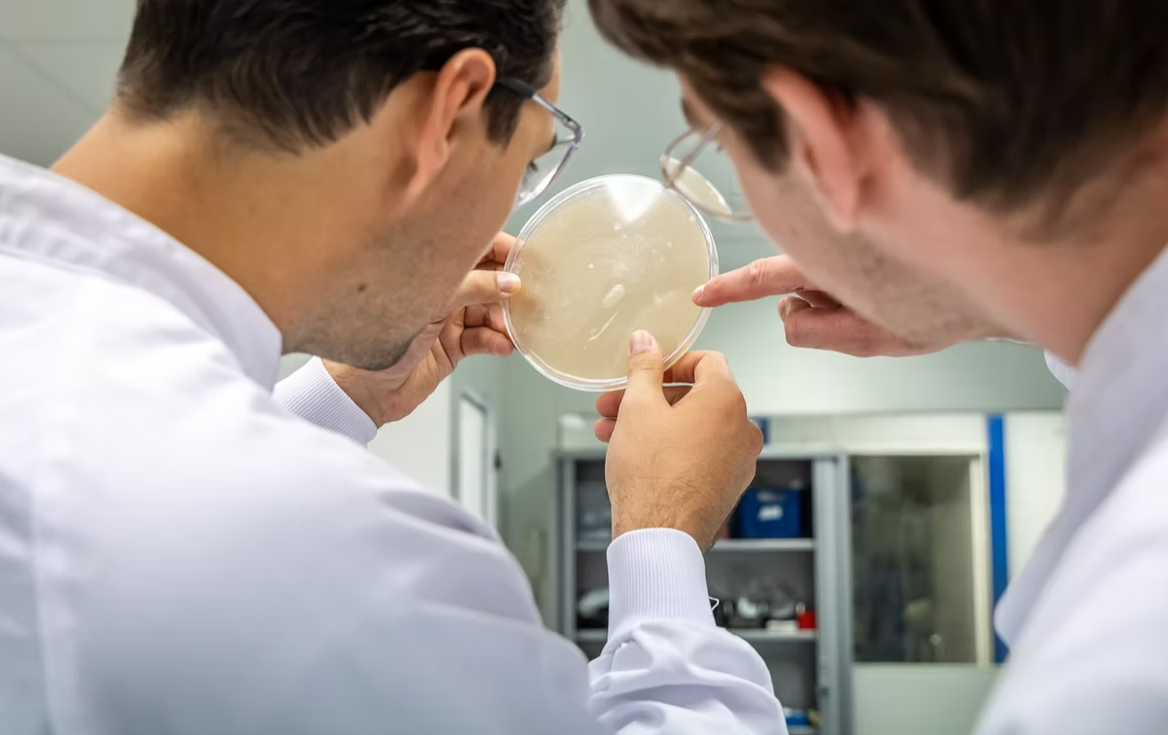

BioscienZ B.V. is een biotechnologiebedrijf, opgericht in 2011 door Wim de Laat. De huidige aandeelhouders, Wim de Laat & Will van den Tweel richten zich op contractresearch op het gebied van fermentatie en industriële biotechnologie.
Dit is waarom BioscienZ B.V. een Groene Pluim verdient
De jarenlange inzet om te werken aan duurzamere oplossingen op het gebied van upgrade c.q. waarderen van reststromen en afvalstromen met daarbij als uitgangspunt echt impact te willen maken is zeer lovenswaardig. Een concreet resultaat hiervan is de oprichting van The Protein Brewery en de impact die BioscienZ hiermee heeft gemaakt in de regio maar zeker ook wereldwijd.
Bij het auditbezoek vielen vanuit de verschillende SDG’s de volgende initiatieven op:
Doel 8: Eerlijk werk en economische groei
De passie om inhoudelijk impact te maken zie je onder andere door de betrokkenheid op het gebied van goed doen voor het personeel. Het team van 10 personen bestaat uit mannen en vrouwen van jong tot oud. De samenwerking en aandacht die uitgaat naar het begeleiden en mede-opleiden van stagiaires om te zorgen dat iedereen zijn of haar diploma behaald is bijzonder. De cultuur van ‘veiligheid voor alles’, samen met ‘fouten maken mag’ en learning on the job zorgt voor een omgeving waar medewerkers zichzelf kunnen ontplooien. Dit wordt actief gefaciliteerd en gestimuleerd. Door de ontwikkelingen en inzet van het bedrijf zijn inmiddels 50 hoogwaardige banen in de regio ontstaan.
Doel 12: Verantwoorde consumptie en productie
Het bewustzijn van het gebruik van materialen die een negatieve impact hebben op het milieu, waardoor de zoektocht naar mogelijke duurzamere alternatieven en het hergebruiken van materialen is een prioritiet. Dit is zelfs doorgevoerd in zoveel mogelijk materialen, apparatuur, instrumenten en inventaris tweedehands aan te schaffen waardoor de levensduur verlengd wordt en het verbruik van materialen geminimaliseerd. Hiermee wordt de R-Ladder niet alleen in het primair onderzoeksproces meegenomen maar ook in de bedrijfsvoering.
Doel 13: Klimaatactie
De impact van de bedrijfsvoering op het klimaat is zeer beperkt. Goed om te vermelden is dat ondanks het beperkt verbruik van gas en elektra er acties in gang zijn gezet om het verbruik inzichtelijk te maken en te reduceren. Zoals de 70 zonnepanelen op het dak waarbij de opgewekte stroom ingezet wordt voor eigen gebruik.
Doel 17: Partnerschap om doelstellingen te bereiken
Alleen met partnerschappen kan BioscienZ opereren en acteren. Het samenwerken in netwerken, opdrachten en consortiums zit in het DNA van de organisatie. Naast de inhoudelijke samenwerking binnen tal van projecten, wordt er ook in regionale netwerken deelgenomen en actief met het onderwijs samengewerkt.
Conclusie
De accreditatiecommissie concludeert dat duurzaamheid diep verankerd is in de cultuur en bedrijfsvoering van BioscienZ. De combinatie van innovatieve oplossingen, maatschappelijke betrokkenheid en duurzame bedrijfsvoering maakt BioscienZ tot een waardige Groene Pluimhouder en een inspirerend voorbeeld voor andere onderzoeksinstellingen.
Pluimhouders: Wim de Laat & Timo van Roosmalen